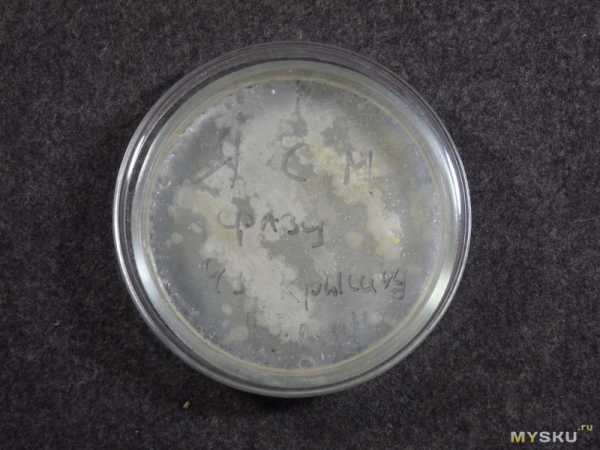
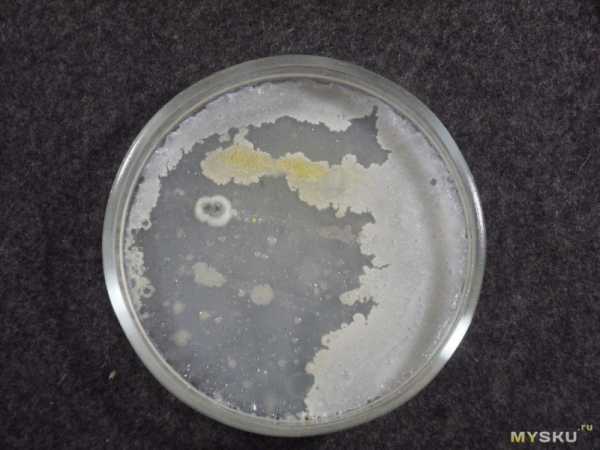

Ультрафиолетовая лампа как работает – Отличие ультрафиолетовой лампы от кварцевой: принцип работы
Как работает ультрафиолетовая лампа и для чего она предназначена
Ультрафиолетовая лампа (УФ) – уникальное изобретение человека, обладающее лечебными и дезинфицирующими свойствами. Лампа состоит из защитной колбы, изготовленной из особого стекла (кварцевого или увиолевого), наполненной парами ртути. При взаимодействии ртути с электрическим разрядом образуется ультрафиолетовое излучение, способное уничтожить всё болезнетворную микрофлору.

Существует несколько видов УФ ламп. Бактерицидная и кварцевая лампы различаются материалом, из которого изготовлена защитная колба. Но у них одинаковый внутренний наполнитель — ртуть.
Бактерицидная лампа – это наиболее безопасный УФ излучатель, который может применяться в жилом помещении. Её защитная оболочка изготовлена из увиолевого стекла препятствующего выделению в воздух озона, опасного для здоровья человека. Благодаря бактерицидной лампе можно предупредить сезонные простудные заболевания, очистить помещение от вредоносных вирусов и поддерживать гигиену жилого помещения. Для повышения безопасности человека современные бактерицидные лампы обрабатывают специальными средствами, увеличивающими её прочность (ударостойкость). Такая лампа не допускает вытекание ртути, токсичной для людей и экологии планеты. Бактерицидная лампа может применяться в жилых помещениях, в лечебных учреждениях, в помещениях с большим количеством людей, в городских массовых заведениях и т.д. для постоянного поддержания санитарных норм и предупреждения вирусных эпидемий. В период использования бактерицидных ламп используются специальные защитные приспособления (очки, защитные щиты, рециркуляторы), оберегающие глаза от травм.
Кварцевая лампа используются в оздоровительных целях и для обеззараживания помещения. Она создана из кварцевого стекла пропускающего ультрафиолетовые лучи в диапазоне 205 – 315 нм. Такого рода ультрафиолетовое излучение обладает повышенными дезинфицирующими качествами, уничтожающими большое количество видов вирусов, грибков, плесени и т.д. В период использования кварцевой лампы необходимо быть внимательным и аккуратным, так как при ее работе выделяется озон. В период дезинфекции, кварцевой лампой, в помещении не должны находиться люди. После обеззараживающей процедуры необходимо тщательно проветрить здание. Кварцевые лампы применяется для дезинфекции лечебных учреждений, производственных мест, пищевых цехов. Эффективно применяется в период эпидемических ситуаций в детских учреждениях, школах, институтах и т.д. В медицине кварцевая лампа обеспечивает эффективное лечение разнообразных болезней (ангины, простуда, аллергия, гайморит и т.д.), применяется для заживления гнойных ран, при обморожениях и ожогах.
Рекомендации экспертов
Чтобы правильно подобрать и купить ультрафиолетовую лампу, необходимо определить для каких целей она приобретается, какую площадь необходимо покрыть, где планируется установить. Большой выбор разнообразных креплений поможет разместить УФ лампу в удобном и безопасном для детей месте. УФ лампы бывают разнообразных мощностей, рассчитанных на дезинфекцию определенного размера помещения.
Перед приобретением лечебной УФ лампой необходимо убедится в полной комплектации прибора. Проверить наличие всех необходимых насадок и их качество, они должны быть упругими и с аккуратно склеенными краями.
В момент покупки УФ лампы внимательно прочитайте пользовательскую инструкцию. Правильная эксплуатация лампы создаст благоприятный микроклимат в помещении и убережет от травм.
На сайте компании «МедМагазин» представлены в широком ассортименте антибактериальные лампы, рециркуляторы и ультрафиолетовые приборы для лечения и дезинфекции помещений.
cikavosti.com
Что нужно знать об УФ-лампах и ультрафиолетовом отверждении, F.A.Q.
Что такое дуговая ультрафиолетовая лампа и как она работает?Ультрафиолетовая дуговая лампа состоит из герметичной кварцевой колбы содержащая газ/металлы и два электрода на разных концах. Импульс высокого напряжения разжигает дугу между электродами (ARC). Тепло от дуги испаряет газы и / или металлы в колбе, образуя плазму. Эта плазма генерирует световую и УФ-энергию.
Как измерить напряжение лампы?
Так как напряжение лампы может превышать безопасный диапазон измерений в большинстве измерительных приборов, необходим специальный прибор для замера высокого напряжения. Коннекторы помещается параллельно лампе. Обычно используется соотношение замера преднастройки 100: 1. Показание напряжение лампы является одним из лучших способов контроля температуры лампы, для нормального его охлаждения (см. охлаждение УФ-лампы).
Как можно узнать, является ли лампа со специальной добавкой?
Если лампа не работает, вы увидите желто-коричневый осадок внутри лампы в дополнение к шарику ртути для Галлиевых ламп (
Вы так же можете посмотреть маркировку лампы на предмет дополнительных кодов.
ПРИМЕЧАНИЕ. Вы не должны смотреть прямо или косвенно на отраженный свет работающей УФ-лампы, так как это ОПАСНО. Если вы посмотрите на «окружающую» область системы отверждения, то можно различить цвет различных добавок: Зеленоватый — Ртутная; легкий оттенок на Пурпурный — с добавкой Галлия; легкий оттенок на Голубой — с добавкой Железа.
Нужно ли использовать УФ-лампу со специальной добавкой?
Вы должны получить консультацию от своего поставщика материала УФ-отверждения, который вы пытаетесь «высушить».
Узнайте, какие ПИКи для полимеризации их материала требуются в УФ диапазоне 390 нм или 420 нм или др.
Почему УФ-мощность излучения падает в процессе эксплуатации лампы?
УФ соляризирует примеси в лампе; Бромид является одним из примеров примеси. Эта соляризация приводит к снижению производительности на 15-20% за первые 20 часов работы лампы. Дополнительное снижение на 10% происходит в следующие 100 часов. Через 120 часов эти потери при передаче остаются постоянными до тех пор, пока не полностью не деградирует лампа.
Почему у некоторых ламп золотое покрытие возле электродов?
Это золотое покрытие в некоторых случаях помогает обеспечить испарение ртути, находящейся в жидком состоянии за электродом; в большинстве случаев это покрытие не требуется.
Что вызывает этот разность рабочих напряжений ламп?
Диапазон напряжения лампы разный, потому, что объем внутри кварцевой колбы изменяется от лампы к лампе при разной геометрии кварца. Это так же влияет на концентрацию газов в лампе, что, в свою очередь, влияет на необходимое напряжение лампы.
Каково обычно время, необходимое для полного розжига лампы в рабочий режим?
Время запуска лампы обычно составляет от 1 до 5 минут. Обратите внимание, что между запусками лампа должна остывать, чтобы ртуть могла снова конденсироваться на стенках до следующего запуска.
Что за серебряный шарик внутри лампы?
Это ртуть. Когда высокое напряжение от балласта подается на лампу, ртуть внутри лампы трансформируется в плазму и генерирует определенной длины волны ультрафиолетовой энергии, которые используются для инициирования полимеризации УФ-отверждаемых чернил и покрытий.
Можно ли использовать более мощную УФ лампу в нашей существующей системе отверждения?
Источники питания и УФ-лампы обычно разработаны и согласованы для обеспечения максимальной производительности. Лампа охлаждается в специально разработанном блоке (кассете) корпуса лампы, который должен обеспечивать соответствующую охлажденную среду для надежной работы лампы. Обычно для модернизации требуется замена как лампы, так и источника питания, системы охлаждения, а также дополнительные модификации блока облучателя лампы (кассеты) для обеспечения соответствующих условий для нормальной работы УФ-лампы.
Что делать, если УФ лампа не запускается при подаче питания?
- Убедитесь, что все соединения плотно скреплены.
- Осмотрите лампу и убедитесь, что ртуть распределена между электродами. Если лампа хранилась вертикально, возможно, что ртуть отложилась за электродом и не входит в плазменный поток. Просто встряхните лампу от конца до конца, чтобы удалить ртуть из-за электродов. Попробуйте снова запустить лампу.
- Колба лампы должна быть герметична, не должно быть трещит, разрыва коннекторов, повреждения изоляции.
- Убедитесь, что источники питания работают правильно.
Что делать, если лампа плохо полимеризирует?
- Убедитесь, что отражатели (рефлектора) уф лампы правильно сфокусированы, имеют чистую зеркальную поверхность.
- Проверьте внешнее загрязнение лампы, которое может иметь налет как: спрей, порошок, материал отражателя или другие частицы прилипшие на лампу.
- Перед запуском убедитесь, что покрытие и материал для чернил полностью перемешаны. Это позволяет равномерно распределять фотоциниатор в по всему УФ-материалу.
- Проверьте количество часов работы лампы. Различные условия приводят к разному сроку службы лампы. Лампы обычно имеют выходную мощность около 80% их первоначальной спецификации через 1000 часов при условии, что лампа работает в соответствующей среде. Если лампа имеет более 1000 часов использования, она не может генерировать достаточную ультрафиолетовую энергию для конкретно для Ваших условий полимеризации (слой, скорость и т.д.).
Изогнутую лампу следует заменить вместе с инспекцией системы охлаждения лампы. Это условие является прямым следствием неправильного охлаждения лампы. Лампу необходимо контролировать, когда температура поверхности находится между 600-800 ° С. Если воздух вокруг лампы не циркулирует должным образом, эта температура будет повышаться, что заставляет кварцевую трубку смягчаться и терять свою жесткость. Отрегулируйте охлаждение и воздушный поток вокруг лампы, чтобы уменьшить температуру колбы лампы. Тем не менее, убедитесь, что колба лампы не охлажден ниже 600 градусов C, так как ниже этой температуры может произойти конденсация ртути из плазмы, которая будет влиять на мощность и производительность лампы, лампа может выйти из рабочего режима.
Процесс УФ-отверждения
УФ-отверждение представляет собой фотохимический процесс, при котором мономеры сшиваются или отверждаются (полимеризуются или перекрещиваются) при воздействии ультрафиолетового излучения. Конкретный мономер будет полимеризоваться при воздействии ультрафиолетового излучения. Этот УФ «отверждаемый» мономер включает фотоинициатор, который поглощает энергию УФ и инициирует реакцию полимеризации в мономере
Пять основных компонентов УФ-система отверждения:
- УФ-источник -> УФ-лампа
- Кассета для УФ-лампы (корпус облучателя)
- Балласт (блок питания)
- Средства для управления (запуск, остановка, открытие шторок, рег-ка мощности)
- Меры защиты (автоматические выключателя, аварийная остановка, датчики перегрева)
Внимание! УФ излучение вредно для кожи и глаз
ULTRAVIOLET RADIATION HARMFUL TO EYES AND SKIN
www.uv-expert.ru
Как работает и что дает ультрафиолетовая бактерицидная лампа для домашнего использования от микробов
Доброго времени суток. Мне в руки, на обзор, попал интересный девайс — компактная защищенная лампа для дезинфекции и стерилизации.В обзор вошли: распаковка, внешний вид, разборка, функционал, возможности, применимость, макро фото, тест аккумулятора, тест на качественное определение озона, тест на бактерицидную эффективность, немного фото и текста.
Согласно описанию, устройство представляет из себя компактную, переносную, автономную, защищённую лампу, излучающую в УФ спектре.
Ее назначение, стерилизация — дезинфекция.
Характеристики:
Рабочее напряжение: 5В, (предельное 5,7 В)
Мощность: 2.5 Вт
Емкость аккумулятора: 800mAh
Рабочий разъем: USB
Время работы одного цикла: 15 минут
Количество циклов от одного заряда батареи — 6-9
Срок службы около 8000 часов.
Размеры 72.5 x 62 x 141mm
Вес 118 грамм.
Рабочая зона около 2 м2
Степень стерилизации 92%
Так как девайс имеет хрупкие части, то коробок упакован в гофрированное газонаполненное полотно из несшитого полиэтилена.

На коробке нанесена простая полиграфия. Изображен внешний вид лампы и характеристики, все на китайском.

Внутри стерилизатор в полиэтиленовом пакете, инструкция и гарантийный талон на китайском.


Форма девайса цилиндрическая с закругленными краями (капсула).
Вся поверхность корпуса покрыты материалом типа soft-tuch.
Половина корпуса — это защитная сетка для U образной лампы, на второй расположена кнопка включения/выключения, ножки. Под сеткой лампа, во второй половине электроника с аккумулятором.






Хорошее определение ультрафиолета дано в Википедии. Ультрафиолетовое излучение (ультрафиолетовые лучи, УФ-излучение) — это электромагнитное излучение, занимающее спектральный диапазон между видимым и рентгеновским излучениями. Длины волн УФ-излучения лежат в интервале от 10 до 400 нм. Статья в вики большая и интересная. Применения ультрафиолета много и самого разного, но нас сейчас интересует только обеззараживающие свойства.
Самым ярков выраженным, бактерицидным, действием обладает ультрафиолет в диапазоне длинны волны от 200 до 295 нм. Пик эффективности в котором приходится на 254 нм (по другим данным 205—315 нм и 265 нм соответственно). Уничтожаются большинство бактерий, грибков, водорослей, обитающих в воздухе и воде. Это происходит в основном за счет димеризации тимина в ДНК(РНК), что приводит к сбою биохимических процессов, мутациям, остановке размножения. В то же время есть некоторые виды бактерий, грибов и прионов, которое УФ-С не уничтожает. В отличие от озона, который уничтожает все живое, даже вирусы. Это происходит потому что озон агрессивный окислитель, акцептор электронов, разрушающий химические связи, часто с образованием свободных радикалов. Озон образуется при облучении кислорода ультрафиолетом с длинной волны менее 200 нм, для отсечения которой используют специальные виды стекла, называемого увиолевым или наносятся специальные пленки на обычное стекло.
Поэтому, совмещая действие озона и ультрафиолета, а также оперируя параметрами условий процесса можно добиться стерильности или хорошей степени дезинфекции.
Аппарат включается трехсекундным зажатием утопленной кнопки — меры предосторожности от случайного включения. Выключение однократным нажатием.

К сожалению, нигде не указана рабочая длинна волны лампы. Но судя по всему это ртутная лампа низкого давления, излучающая в «бактерицидном» и «озонообразующем» интервале длин волн. Под это описание, например, подходят некоторые люминесцентные лампы без люминофорного покрытия (два пика 254 нм и 185 нм, 90% и 10% соответственно).
Но более точно, мне сложно сказать.

Ножки имеют ограничения — их нельзя развести более чем на 90 градусов относительно друг друга.

Разборка
Разборка девайса не представляет труда. Вначале снимается защитная сетка.

В корпусе, установлены две пластиковые заглушки, под которыми находятся крепёжные винты.


После выкручивания которых крышка корпуса легко открывается.

В корпусе расположен аккумулятор

дроссель

Видно usb разъем в глубине,

управляющая плата (установлена в пазы на корпусе).

Полевые испытания аккумулятора, показывают емкость, соответствующую заявленной.

Макро

Тестирование
При включении лампы ощущается слабый, но характерный запах озона. Проведем качественный тест на озон. Это классический и широко известный метод. Он основан на двух реакциях — выделение йода при воздействии озоном на иодид калия в водном растворе, и реакция йода с крахмалом.
Вторая реакция — это так же качественная реакция на крахмал. Который недобросовестные производители могут подмешивать в продукты. Например, творог.
На фото капля йода на срезе клубня картофеля и на крахмале домашнего приготовления приобретает характерный синий цвет. Внизу капля раствора йода для сравнения, на лезвии ножа.
Можно использовать, пропитанную раствором этих реагентов, бумагу — ее можно купить или сделать самому (перед использованием смачивается водой) или собрать лабораторную установку и эффектно пропускать газ через раствор.
Но что бы не тратить время и деньги, упростим эксперимент. Так как озон тяжелее воздуха, поместим аппарат в емкость в которой он сможет скапливаться.
Где взять иодид калия? В виде растворов или таблеток он используется в фармакологии. Применяется как антитиреоидное, муколитическое, отхаркивающее, противогрибковое, радиопротективное (предотвращает поглощение щитовидной железой радиоактивного йода) средство.
Йодированная соль, это соль, как правило, с добавлением, в том числе и иодида калия.
Вещество можно купить в магазине химреактивов, даже фармакопейной чистоты.
Готовая смесь.
Сразу возникает вопрос — почему же тогда озон не скапливается у поверхности земли, если он тяжелее воздуха? Расположенный на высоте в несколько десятков километров, неравномерным и очень разбавленным слоем, озон практически полностью разлагается и не успевает достичь обитаемого дна воздушного океана. Этому способствует не высокая стабильность молекулы озона и разложение его под действием средневолнового ультрафиолета.
Как говорится — где родился, там и пригодился.
Но все-таки небольшое количество озона всегда присутствует в нижних слоях атмосферы — это тропосферный и смоговый озон.
Включаем лампу и опускаем ее в емкость.
В верхних слоях атмосферы озон большое благо — уже миллионы лет укрывает хрупкую жизнь от жёсткого ультрафиолета. Контролируемое использование его, приносит много выгод, но в нижних слоях атмосферы это загрязнитель. И если комнату можно проветрить от озона, то улицу нет. Продолжительное дыхание таким воздухом может стать причиной хронических болезней органов дыхания и других органов.
Через некоторое время видим результат — смесь потемнела.
На этой фотографии хорошо видно сразу обе реакции. В верхней части — коричневый элементарный йод, а в нижней синий комплекс — клатрат.
Вывод: при работе лампы действительно выделяется озон.
Следует сказать, что озон относится к I классу опасности. Это токсичное и пожароопасное вещество! Очень жесткий окислитель, хотя и очень нестойкий. Все дело в том, что в домашних условиях, этой лампой, вы не сможете его собрать, сохранить, сконцентрировать так и столько, чтобы использовать как оружие массового поражения. Но это не значит, что не нужно соблюдать правила безопасности.
Какое все-таки время разложения озона? Попадались статьи в интернете, о полураспаде за 3 суток при температуре 20 градусов.
Субъективно, для обозреваемого устройства, сразу после цикла работы в помещении, чувствуется специфический запах озона. Со временем запах значительно ослабевает и часа через 2-3 чувствуются только его следы. Проветривание в разы помогает ускорить этот процесс.
Почему так отличаются данные? Кто-то врет? Не думаю. Возможно различия в методике эксперимента. Скорее всего, в лаборатории, химически стойкую емкость, наполнили озоном, замерили концентрацию и температуру. Через время делая замеры, получая приведенные выше результаты.
В быту лампа контактирует со смесью азота и кислорода ограниченное время. После выключения озон диффундирует в объеме помещения постоянно реагируя с другими молекулами и разлагаясь — поэтому время меньше. Добавьте сюда размешивание и разбавление проветриванием, и концентрация снизится еще сильнее.
Что бы исключить фокус, со спрятанным «разрядным» озонатором в корпусе (мелькнула и такая мысль), был проведен очень простой эксперимент. Отделим мембраной (полиэтиленовый пакет) лампу от корпуса. Результат: после кратковременного включения со стороны лампы чувствуется явный запах озона, со стороны корпуса — нет. Вывод: честная УФ лампа, излучающая в коротковолновом диапазоне.
Жесткий ультрафиолет опасен не только для микроорганизмов. С тем же успехом он поражает и ткани растений и многоклеточных организмов. Но его эффективность зависит от интенсивности излучения и времени выдержки.
Кстати ультрафиолет не видим для человеческого глаза, а за характерное голубое свечение, отвечают пары аргона, присутствующие в трубке.
Далее тест на бактерицидную эффективность.
Это первый опыт создания и засева питательной среды, так что не судите строго. Методика называется «с миру по нитке и на коленке». И хотя были допущены две серьезные ошибки, методика в целом рабочая — результат был получен.
Подготавливаем стеклянные чашки Петри.
Проводим предварительную стерилизацию в кипящей воде.
Параллельно готовим бульон. Берем куриную голень и развариваем до состояния, когда мясо будет отваливаться от кости.
В лабораториях используют специальный агар. Это отличный и… дорогой препарат, поэтому берем кулинарный.
На следующем этапе в кипящий бульон (примерно 360 мл)постепенно, помешивая всыпаем 9 грамм агара.
На этом этапе я допустил первую ошибку — использовал не фильтрованный бульон. 
Когда весь агар растворится — разливаем его по чашкам Петри.
Получается натуральная питательная среда неопределенного состава.
Технически, колонию бактерий можно получить и на чистом агаре, но добавление бульона должно ускорить процесс.
Далее чашки Петри с питательной средой следует окончательно стерилизовать.
Из-за отсутствия автоклава, я делал это в кастрюле с небольшим количеством воды и чашками сложёнными на тарелке стопкой. Кипятим около часа.
После завершения процесса на внутренней поверхности крышек чашек образовались капли конденсата, который со временем впитался в слой агара.
Для засева питательной среды берем образцы бактерий с мочалки, смартфона, пальцев.
Всего было подготовлено 6 чашек. Два эталона — чистый и грязный. Два образца были загрязнены сразу. Один обрабатывался 15 минут лампой при открытой крышке
второй обрабатывался лампой через толстую крышку чашки Петри из каленого стекла.
Еще два заражены бактериями изначально, для исследования динамики после обработки.
Далее подписываем все образцы
и упаковываем в пищевую пленку.
В силу обстоятельств, промежуточные этапы провести не удалось.
Через 7 суток смотрим результат. Образцы располагались в темном месте при температуре 20-22 градуса. И это вторая вынужденная ошибка — такая температура не оптимальная для размножения бактерий (желательно 35 градусов). Но в итоге это не повлияло на результат, просто он получился менее зрелищным.
В итоге были получены следующие результаты:
Образец обработанный с закрытой крышкой — колонии бактерий, плохой запах.
Образец обработанный с открытой крышкой — отсутствие следов жизнедеятельности или незначительное их количество, запах бульона.

Чистый контроль — отсутствие следов жизнедеятельности микроорганизмов, приятный бульонный запах.

Грязный контроль — образование колоний бактерий, запах разложения.
Выводы. Лампа эффективно обеззараживает. Но УФ-С эффективен на поверхности, а озон справился даже с вторичным засевом из воздуха.
Описание опыта будет не полным если не сказать, что содержимое чашек Петри следует уничтожить прежде чем выбрасывать. Это важное правило биологической безопасности, предотвращающее отравление продуктами жизнедеятельности бактерий или заражение ими. Обычно рекомендуют использовать хлорную известь, но у меня, из серьезных антисептиков, был только этиловый спирт.
Так же аппарат можно использовать для дезодорации.
Было два случая проверки. Первый — на кухне, после жарки речной рыбы. Навязчивый, всепроникающий запах. Окна не открывались, вытяжка не включалась, дверь была закрыта. После 15 минут работы уровень запаха жареной рыбы значительно уменьшился, хотя полностью и не исчез. После короткого проветривания воздух в помещении нормализовался.
Второй — испытание на образце в чашке Петри. Образец с «грязной» пробой имел явный гнилостный запах. После 15 минутной обработки неприятные запахи полностью исчезли.
Общий вывод.
Это не очень мощная лампа (например, сейчас популярны подобные бактерицидные лампы мощностью не менее 15 Вт), но компактная и автономная.
Озона от излучения образуется меньше, чем от разряда, но он чище — без окислов азота…
Аппарат позволяет, с некоторыми ограничениями, обрабатывать практически любые бытовые цели. Холодильники, шкафы для обуви и одежды, сырые места, пораженные плесенью, салон автомобиля, предметы, вещи и т.д.
Так же лампа должна подойти для стирания памяти EPRO.
Использовать в самоделках? Почему бы и нет. Например, воздушный дезинфектор с принудительной циркуляцией и катализатором разложения озона. Такая конструкция позволит дополнительно, эффективно чистить воздух от монооксида углерода и летучей органики. Из катализаторов читал об активированном угле или можно купить готовые промышленные катализаторы разложения озона.
Аналогично и для воды. Только учитывая, что УФ-С в воде обеззараживает не очень глубоко и не образуется озон.
Некоторые химические реакции проходят только под УФ-С или ускоряются.
Можно использовать эту лампу для дезинфекции обуви?
Можно, но с некоторыми оговорками. Казалось бы, хотя обувь и делается из материалов не прозрачных для УФ-С, но озон проникает вглубь материала и все отлично дезинфицируется. Но в то же время и ультрафиолет и озон ускоряют старение некоторых материалов, используемых при изготовлении обуви. Чувствительны к УФ излучению: полипропилен, полиэтилен, оргстекло, ароматический полиамид. К озону список еще больше, но играет роль температура, концентрация и другие условия. В любом случае признаки старения не будут проявляться моментально. Пластик на солнце выгорает (стареет) месяцами. В нашем случае среда более агрессивная, но и время контакта в разы меньше. Для дезинфекции и дезодорации такого небольшого объема столько времени не нужно.
В любом случае общие рекомендации будут такими:
— Перед дезинфекцией обязательно сушить обувь.
— Но не на радиаторе отопления, а специальными сушилками.
— Включать стерилизатор на короткое время — это можно определить опытным путем.
— После обработки хорошо проветрить обувь — продуть той же сушилкой.
При таких условиях эффект старения будет минимальным.
Внимание! Использование данного устройства требует соблюдения правил безопасности, нарушение которых может причинить вред вашему здоровью.
1. Минимизировать облучение кожи лампой — особенно с близкого расстояния и длительное время
2. Не смотреть на включенную лампу — особенно с близкого расстояния и длительное время.
3. Не вдыхать смесь воздуха с озоном. На время работы лампы закрыть помещение и покинуть его на время необходимое для разложения озона. После — проветрить помещение.
При грамотном использовании аппарата, опасность он представляет не больше чем бытовой газ или электрический ток.
Спасибо за внимание!
Товар предоставлен для написания обзора магазином. Обзор опубликован в соответствии с п.18 Правил сайта.
mysku.ru
Ультрафиолетовые лампы – принцип работы и применение » Бизнес журнал
Принцип работы ультрафиолетовой лампа основан на тех же процессах, что и работа обычной люминесцентной лампы. Под воздействием электричества пары ртути начинают светиться. Сам корпус лампы изготавливается из специального стекла, которое может пропускать ультрафиолетовые лучи. Длину волны ультрафиолета можно менять именно с помощью стекла. Вместе со сменой диапазона светимости меняются и свойства ультрафиолетового света. В основном сегодня используют увеолевое стекло, которое позволяет гибко работать с длинной волны.Применение ультрафиолетовых ламп
Такие лампы применяются во многих сферах жизни человека.
Медицина – остается одной из главных отраслей применения УФ-ламп. Они используются для бактерицидной обработке помещений. Сегодня в каждом медицинском учреждении и даже в дошкольных учреждениях установлены УФ лампы.
Косметология – используется для всем известного способа нанесения загара в соляриях. Здесь обязательна сертификация ламп для такого применения, так как ультрафиолетовый свет может нанести непоправимое здоровье человеку при неправильном применении. Кроме того эта уф лампа используется для быстрой сушки поляризующего лака в процедуре наращивания ногтей.
Обработка питьевой воды – уф свет благодаря своему бактерицидному действию способен эффективно очищать питьевую воду. Сегодня использования хлора для очистки уходит в прошлое и на смену ему приходят специальные рециркуляры на основе УФ-ламп.
Очистка воздуха от бактерий – в больших промышленных помещениях, где скапливается много людей для эффективной очистки воздуха используют закрытые рецилькуляры с уф-панелями. Такие панели, установленные в системе вентиляции, позволяют очистить воздух от вредоносных бактерий.
В полиграфии – для быстрой сушки краски и изменения ее структуры, что позволяет получать более выразительные и яркие цвета. Кроме того полиграфия после обработки уф-излучением лучше противостоит царапинам и выгоранию.
Проверка купюр – для проверки подлинности денежных знаков используют приборы с ультрафиолетовыми лампами. На сами деньги наносят специальные водяные знаки, которые проявляются только под уф-излучением.
В криминалистике уф лампы используют для выявления различных веществ: крови, спермы, взрывчатки. Основа такого метода – свечение веществ под воздействием уф волн.
iseekmate.com
польза и вред, чем опасен ожог для человека
Ультрафиолетовые приборы используются в медицине, полиграфии, криминалистике, косметологи и других сферах деятельности.
Ультрафиолетовое излучение, не смотря на многие свои полезные свойства, при чрезмерном воздействии способно вызвать ожоги и другие необратимые изменения в организме.
Польза
Их применяют для лечения артрита, воспалительных заболеваний органов дыхания, стоматита, гнойных ран и других заболеваний, обеззараживания помещений, бактерицидной обработки воды, а также при уходе за домашними животными и комнатными растениями.
В настоящее время большой популярностью пользуются лампы в соляриях для придания коже ровного загара. Широкое распространение получили лампы для маникюрных салонов, так как они способствуют затвердеванию геля на ногтях и защищают ногти от грибка и различных бактерий.
Есть ли опасность от уф излучателей?
О безопасности использования УФ ламп можно судить по мощности излучения и материалу, из которого они изготовлены.
Кварцевые облучатели
Используются для обеззараживания, способны уничтожать болезнетворные вирусы и микробы. Но являются самыми опасными для живых организмов.
Во время работы кварцевой лампы происходит выделение озона, который сильно окисляет воздух, становится очень токсичным и повреждает органы дыхания.
Читайте более подробно о кварцевых излучателях.
ВАЖНО! Применение ртутно-кварцевых ультрафиолетовых ламп в присутствии людей или животных недопустимо и опасно для жизни! Более подробно о возможном вредном воздействии кварцевой лампы.
Бактерицидные УФ лампы
Производятся из увиолевого стекла, которое отфильтровывает озонообразующие волны. Такие лампы можно применять в домашних условиях. Но бактерицидные свойства слабее, чем у кварцевых ламп, поэтому рекомендуется более длительное использование.
Читайте также: бактерицидные лампы.
Амальгамные приборы
Лампы амальгамного типа имеют ряд достоинств. Они наиболее безопасные для окружающей среды, так как ртуть находится внутри в связанном, а не жидком состоянии. При этом амальгамные лампы очень мощные и эффективно справляются с задачей обеззараживания.
Вред в виде ожога при использовании УФ лампы
При долговременном действии ультрафиолета можно получить термические ожоги глаз и кожи.
В зависимости от степени тяжести ожога возможно проявление следующих симптомов:
- болезненные ощущения;
- зуд и жжение;
- припухание и отечность век;
- покраснение слизистой оболочки и кожных покровов;
- слезотечение;
- светочувствительность и светобоязнь;
- ухудшение зрения;
- образование корок и волдырей.
ВНИМАНИЕ! При получении термического ожога необходимо срочно обратиться за квалифицированной медицинской помощью!
Кроме ожога возможно проявление аллергической реакции в виде сыпи.
Как обезопасить человека от вредного излучения?
- Использовать ультрафиолетовые лампы только по назначению врача.
- Проконсультироваться со специалистом, чтобы правильно подобрать прибор для конкретных целей.
- Внимательно изучить технические характеристики и инструкцию.
- Мощность лампы должна соответствовать размерам помещения.
- Использовать закрытые лампы или специализированные приборы, так как они наиболее безопасны для людей.
- Не оставлять без присмотра детей и животных во время процедуры!
- Использовать специальные защитные очки и средства во избежание серьезных ожогов.
- После использования проветривать помещение.
ВАЖНО! Необдуманное применение ультрафиолетовых приборов и халатность влекут за собой печальные последствия.
Необходимо помнить, что ультрафиолетовое излучение способно годами накапливаться в организме человека. Поэтому его регулярное воздействие вызывает старение кожи и увеличивает риск развития рака кожи и глаз, а также других опасных заболеваний.
osvescheniepro.com
Виды ультрафиолетовых ламп и их применение в быту и не только
Содержание статьи:
Бактерицидные лампы широко используются в различных отраслях: медицине, пищевой промышленности, косметологии и фармакологии. В их основе работы лежит губительное воздействие ультрафиолета на микроорганизмы. Это уникальный способ обеззараживания воздуха и поверхностей в помещении.

Разновидности бактерицидных ламп
Они подразделяются на озоновые и безозоновые. За счет наличия спектральной линии в спектре излучения первые при взаимодействии с кислородом образуют озон. Его высокая концентрация негативно воздействует на здоровье людей. При установке озоновых бактерицидных ламп необходимо строго контролировать уровень озона в воздушной среде и часто проветривать помещение.
В безозоновых лампах колба изготавливается из кварцевого стекла со специальным покрытием. Благодаря этому материалу исключается риск генерации озона. Ее использовать можно только в помещениях, где нет людей и растений. Однако такая лампа способна за небольшой период устранить из воздуха в помещении вредоносные бактерии.
Второстепенная классификация:
- По принципу мобильности бактерицидные лампы могут быть переносными и стационарными. Первые легко перемещать из помещения в помещение, вторые крепятся в определенной комнате. Они широко используются в медицинских учреждениях.
- По принципу работы лампы могут быть открытого и закрытого типа. Модели открытого типа рассеивают свет по всему помещению, а закрытого типа — только на определенный объект. Второй вариант безопасен для человека и растений. Иногда такие модели оснащаются вентилятором.
- По способу крепления лампы могут быть напольными, настенными и настольные. Последний вариант применим для небольших помещений. Благодаря различным модификациям такие лампы могут быть достойным украшением интерьера.Настенные или навесные лампы используются для обеззараживания средней комнаты, напольные устанавливаются в больших помещениях.
Какие бактерицидные лампы подходят для домашнего использования?
В домашних условиях возможно использование:
- излучателей для обеззараживания воды;
- приборов, обеззараживающих воздух и поверхности в помещении;
- маломощных ламп.
Излучатели устанавливаются в узлах водопровода. Они убивают микроорганизмы и простейшие водоросли. Такой способ очистки воды эффективнее, чем хлорирование. В результате него в жидкости не остаются примеси.

Утрафиолетовый очиститель воды для общественных нужд
Представители второго типа в основном сочетаются с ионизаторами воздуха. Это приборы закрытого типа. Бактериальные лампы обеззараживают воздух и насыщают его ионами. В них нет открытого излучения, поэтому они могут использоваться при нахождении в помещении людей.

Дезинфекция воздуха ультрафиолетовой лампой
Маломощные лампы применяются для профилактики заболеваний, вызванных недостатком солнечного света. При их использовании необходимо позаботиться о средствах защиты глаз.
Установка и использование в общественных помещениях
Ультрафиолетовые бактерицидные лампы устанавливаются в местах большого скопления людей с целью предотвращения распространения возбудителей инфекций. Их монтаж производится в обязательном порядке в дошкольных и школьных учреждениях, лечебных и общественных организациях.
При вводе бактерицидных ламп в медицинских учреждениях необходимо присутствие специалистов санитарно-эпидемиологической службы.
Помещения, в которых устанавливаются бактерицидные лампы, должны соответствовать следующим требованиям:
- его высота должна быть не менее 3-х метров;
- в местах постоянного скопления людей необходимо применять лампы закрытого типа, которые безвредны для находящихся в помещении лиц;
- должны быть оснащены системой вентиляции или оконными проемами для проветривания;
- температура воздуха в них превышает 10 градусов;
- напольные и настенные поверхности должны быть изготовлены из материалов, которые не боятся ультрафиолета.
На помещения, в которых устанавливаются бактерицидные установки, должен быть составлен акт и заведен журнал контроля. В последнем документе указывается периодичность проверок, продолжительность работы ультрафиолетовых ламп и концентрация озона в помещении при их функционировании. В нем вписывается прошедший инструктаж персонал, ответственный за безопасность работы бактерицидной установки.

Размещение ультрафиолетовой лампы в медицинском помещении
При эксплуатации бактерицидных ламп в общественных местах стоит помнить о некоторых особенностях:
- лампы закрытого типа должны быть установлены на расстоянии до 2 метров от пола по ходу основных воздушных потоков;
- протирка ламп от пыли осуществляется только после отключения от сети;
- для определения срока их службы используются электрические счетчики или радиометры.
- Как правильно пользоваться бактерицидными лампами?
Озон, выделяющийся при их работе, является отравляющим газом. При использовании бактерицидных ламп стоит помнить правила безопасности:
- Желательно покидать помещение при включении лампы. В нем нельзя находиться без специальных очков.
- Нельзя оставлять в комнате животных и растений на период работы лампы, так как она излучает жесткие ультрафиолетовые лучи.
- Продолжительность работы лампы для дома не должна превышать 30 минут. В комнату можно заходить только через час после процедуры.
- Рекомендуется использовать бактерицидные лампы для дома не чаще 1 раза в неделю.
- Нельзя использовать лампу не по назначению, например: для загара. Такие действия приведут к серьезным последствиям.
- Перед применением маломощных ламп для профилактики и лечения болезней необходимо прочитать инструкцию и проконсультироваться с врачом.
- Уход за лампой должен осуществляться только после отключения ее из сети.
Техника безопасности и предостережение об опасности ультрафиолета для здоровья
Основные тезисы техники безопасности при использовании бактерицидных ламп изложены в Инструкции по охране труда. В соответствии с ней в общественных помещениях к работе с бактерицидными лампами допускаются лица, достигшие совершеннолетия и имеющие соответствующие знания (прошедшие специальную подготовку). Инструктаж знаний проводится не реже 1 раза в 6 месяцев.
Персонал, обслуживающий бактерицидные установки, должен быть оснащен средствами индивидуальной защиты: специальными очками, халатом, перчатками и маской.
При обнаружении неисправностей или отсутствия средств защиты уполномоченное лицо обязано сообщить руководству. При возникновении несчастного случая принимаются неотложные меры для его предотвращению и оказанию первой помощи пострадавшим.
При работе с бактерицидными установками в общественных местах должны быть учтены следующие требования:
- обеззараживание помещения может проводиться в присутствии и отсутствии персонала;
- при присутствии персонала в период работы лампы облучатели должны иметь защитный экран;
- если в помещении нет вентиляции, то после 1,5 часа работы бактерицидной лампы необходимо проветрить помещение;
- в период обеззараживания необходимо повесить табличку над дверью «Не входить! Идет обеззараживание помещения!»;
- нельзя самостоятельно осуществлять замену бактерицидных ламп, этим должен заниматься электротехнический персонал;
- лампы, пришедшие в негодность, необходимо хранить в контейнерах и передавать на утилизацию в специальные компании.
Нельзя:
- использовать бактерицидные лампы, которые не имеют сертификата;
- прикасаться к лампе в период работы влажными руками;
- эксплуатировать запыленные лампы, так как сокращается их интенсивность облучения.
Бактерицидная лампа незаменима для помещений общественного назначения, так как в них скапливается большое количество бактерий. Эксперты сделали замеры, по которым выявили, что в классе, в котором проходит школьный урок количество бактерий увеличивается в 5 раз. При подсчетах было выявлено, что на начало урока количество микроорганизмов составляет около 2000, а на конец — превышает 10000.
Что касается ламп для домашнего использования, то особой нужды в них нет. Исключение составляют случаи, когда в семье есть дети с пониженным иммунитетом или старики, а также проживающие в районах Крайнего Севера (полярная ночь достигает 4 месяцев). Чрезмерная стерилизация в доме ведет к снижению защитных функций организма.
Вконтакте
Google+
Одноклассники
Мой мир
Поделиться ссылкой:
indeolight.com
Как работает УФ-лампа для ногтей? ~ Похуделка.ру
Мы все благодарны нашим УФ-гелям за то, что можно сделать « французский маникюр » дома. Но знаете ли вы науку, лежащую в основе процесса упрочнения геля?
УФ-излучение ( ультрафиолет ) имеет несколько характеристик, но наиболее важным является его длина волны.
УФ-свет является частью спектра света, невидимого человеческим глазом. Подумайте о Ultra-звуках, которые мы не можем слышать из-за очень высоких частот. Этот свет измеряется на длине волны и составляет от 100 до 400 нм. Наш глаз может видеть свет в диапазоне от 400 до 780 нм.
Для той же длины волны ультрафиолетового излучения интенсивность света может изменяться. Это напрямую зависит от мощности лампы. Существуют различные варианты УФ-ламп: от 9 Вт до 75 Вт для профессиональных моделей. Ультрафиолетовая лампа мощностью 36 Вт самая популярная.
Вам также понравится: как выбрать лампу для гель-лака — http://noelle.ru/manicure/kak-vyibrat-lampu-dlya-gel-laka/.
Важно также знать, что чем больше ламп, тем выше интенсивность света даже при малой мощности. Важную роль играет также расстояние между ногтями и УФ-лампой. Чем дальше ногти от света, тем медленнее гель затвердевает. Если блистеры находятся слишком далеко от ногтей, гель вообще не может затвердеть.
Все эти характеристики оказывают значительное влияние на УФ-отверждение геля, поскольку производители используют химические молекулы в своих гелях, называемых «фотоинициаторами». Эти «фотоинициаторы» реагируют при воздействии определенной длины волны ультрафиолетового излучения. Вот почему очень важно использовать специально разработанную УФ-лампу для ногтей, чтобы полимеризация УФ-геля проводилась в лучших условиях.
Когда «фотоинициатор», содержащийся в УФ-геле, подвергается воздействию длины волны и интенсивности, он высвобождает частицу, называемую «свободные радикалы». Этот «свободный радикал» инициирует реакцию полимеризации со смолой, содержащейся в геле. Эта реакция полимеризации выделяет тепло (ощущение жжения). Мы говорим здесь об «экзотермической» реакции («экзо», что означает «снаружи» и «термо» — «тепло»). Производители УФ-гелей утверждали, что это чувство тепла обусловлено трением между молекулами. Эту экзотермическую реакцию можно, тем не менее, контролировать простым способом.
Лучший способ уменьшить это чувство жары — держать ногти довольно далеко от лампы, чтобы начать реакцию «фотоинициаторов». Обычно достаточно размещать ногти прямо перед входом УФ-лампы, этого будет достаточно. Когда цикл затвердевания геля начинается, ногти должны находиться рядом с лампой каждые 15 секунд или около того.
Последнее, что очень важно. Очень важно помнить, что производители Ультрафиолетовых гель-лаков знают силу и интенсивность света, необходимые для упрочнения их продуктов. Поэтому, если производитель указывает, что его гель затвердевает с лампой мощностью 9 Вт, этого будет достаточно. Если, с другой стороны, рекомендуется использовать лампу 36 Вт для реакции, даже не пытайтесь использовать лампу 9W, рискуя ждать очень долго даже до начала реакции. Эта информация очень важна для учета, поскольку не все ультрафиолетовые лаки для ногтей эквивалентны и не все обладают одинаковой производительностью. Все гели разные, и все они реагируют на разную интенсивность света.
pokhudelka.ru
